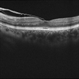

-
 By Jeffrey G. Gross, MD, FASRS
By Jeffrey G. Gross, MD, FASRS
- Uploaded on Oct 8, 2012.
- Last modified by Jeffrey G. Gross, MD, FASRS on Oct 8, 2012.
- Rating
- Appears in
- Miscellaneous
- Condition/keywords
- rubella retinopathy, 20/25
- Description
- Rubella retinopathy, 20/25.


 Initializing download.
Initializing download.